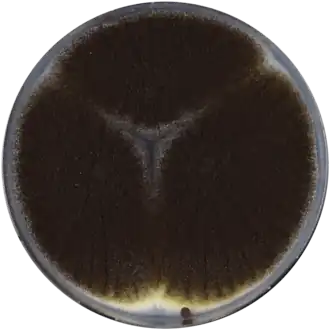
Колонии аспергилла чёрного (анаморфа)

Эуроциевые
| Эуроциевые | ||||||||||||
|---|---|---|---|---|---|---|---|---|---|---|---|---|
Колонии аспергилла чёрного (анаморфа) | ||||||||||||
| Научная классификация | ||||||||||||
|
Домен: Царство: Подцарство: Отдел: Подотдел: Класс: Подкласс: Eurotiomycetidae Порядок: Эуроциевые |
||||||||||||
| Международное научное название | ||||||||||||
| Eurotiales G.W.Martin ex Benny & Kimbr., 1980 | ||||||||||||
| Синонимы | ||||||||||||
|
||||||||||||
| ||||||||||||
Эуро́циевые (лат. Eurotiáles) — порядок грибов отдела аскомицетов. Относится к классу Eurotiomycetes.
Характеристика
Аски почти округлые, аскоспоры линзовидные, часто с двумя экваториальными гребнями. Плодовые тела — как правило, клейстотеции, иногда редуцированные. У Paecilomyces аски образуются в рыхлых структурах (прототециях) прямо на гифах мицелия. У Talaromyces плодовые тела представляют собой скопления неутолщённых гиф (так называемые гифотеции). У Trichocoma и Pseudotulostoma клейстотеции не образуются, аски располагаются на строме. Наиболее крупные плодовые тела у Elaphomyces, достигают 3 см в диаметре.
Преимущественно сапротрофы, в роду Elaphomyces — микоризообразователи.
Представители некоторых родов образуют анаморфы, наиболее известны анаморфы Penicillium, Aspergillus. Для многих из них описана только анаморфная стадия. Некоторые виды — ксеротолеранты и осмотолеранты.
Среди представителей порядка — продуценты токсинов патулина, охратоксинов, афлатоксинов.
Таксономия
Eurotiales G.W.Martin ex Benny & Kimbr., Mycotaxon 12 (1): 23 (1980).
Семейства
- Aspergillaceae
- Elaphomycetaceae — Элафомицетовые
- Thermoascaceae
- Trichocomaceae — Трихокомовые
Примечания
Литература
- Geiser D. M., Gueidan C., Miadlikowska J. et al. Eurotiomycetes: Eurotiomycetidae and Chaetothyriomycetidae // Mycologia. — 2006. — Vol. 98 (6). — P. 1053—1064.